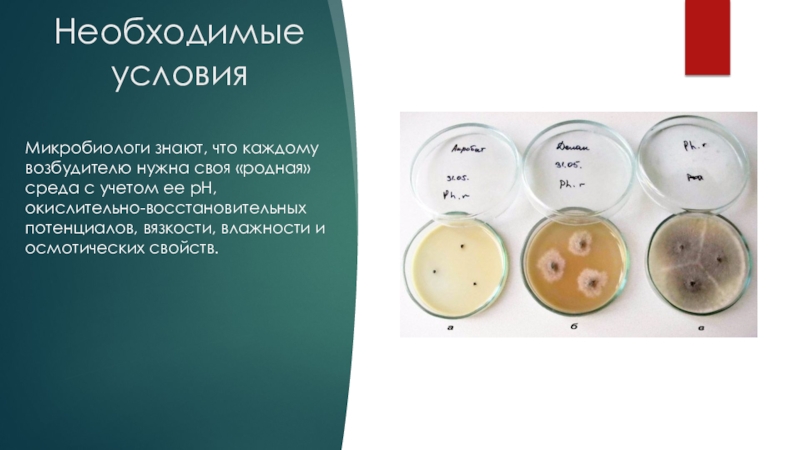
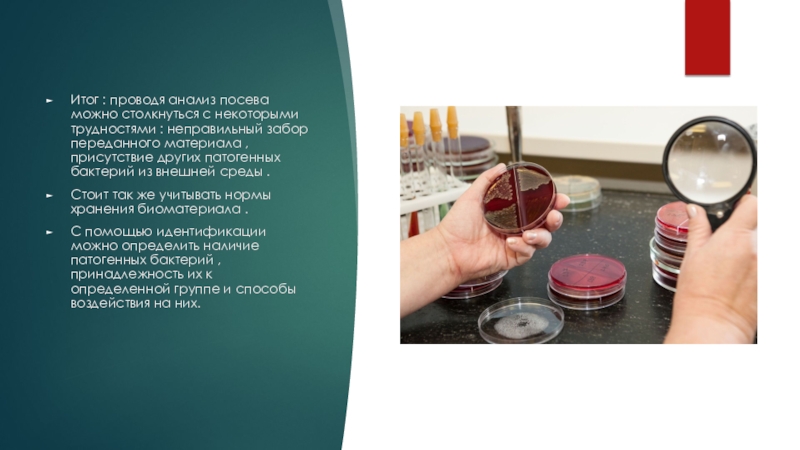

А.В.
Проверил преподаватель по микробиологии:
Лаврентьева Л.В
- Главная
- Разное
- Образование
- Спорт
- Естествознание
- Природоведение
- Религиоведение
- Французский язык
- Черчение
- Английский язык
- Астрономия
- Алгебра
- Биология
- География
- Геометрия
- Детские презентации
- Информатика
- История
- Литература
- Математика
- Музыка
- МХК
- Немецкий язык
- ОБЖ
- Обществознание
- Окружающий мир
- Педагогика
- Русский язык
- Технология
- Физика
- Философия
- Химия
- Шаблоны, фоны, картинки для презентаций
- Экология
- Экономика
Презентация, доклад на тему Анализ посева и идентификация
Содержание
- 1. Анализ посева и идентификация
- 2. Необходимые условияМикробиологи знают, что каждому возбудителю нужна
- 3. Среды могут быть мягкими и твердыми, простыми
- 4. Некоторые среды (тиогликолевая, Сабуро) подходят для широкого
- 5. Цель культивирования микроорганизмов и значимость ее для
- 6. Постоянными обитателями, не несущими никакой опасности человеку,
- 7. Условно-патогенной флорой, которая приносит вред лишь в
- 8. Наличие патогенных микробов Наличием патогенных микробов, которые
- 9. Когда назначается бак посев и как разобраться
- 10. 1. Первым пунктом заключения, как правило, стоит название
- 11. 2.Следующий пункт – концентрация микроорганизма. Е. coli– обильный рост (1х10^6 и более) норма – менее 1x10^4;
- 12. 3.Далее – патогенность: флора условно-патогенная.
- 13. При исследовании биологического материала на присутствие патогенных
- 14. Иной раз, в зависимости от того, какой
- 15. Правильная подготовка к бактериологическому анализуБактериологическому анализу может
- 16. Правильная подготовка к бактериологическому посеву будет залогом
- 17. Биохимическая идентификация Классический (традиционный) метод идентификации микробов
- 18. Биохимические и молекулярно-генетические методы идентификацииХемоидентификация — идентификация
- 19. Итог : проводя анализ посева можно столкнуться
- 20. Спасибо за внимание !
Необходимые условияМикробиологи знают, что каждому возбудителю нужна своя «родная» среда с учетом ее рН, окислительно-восстановительных потенциалов, вязкости, влажности и осмотических свойств.
Слайд 2Необходимые условия
Микробиологи знают, что каждому возбудителю нужна своя «родная» среда с
учетом ее рН, окислительно-восстановительных потенциалов, вязкости, влажности и осмотических свойств.
Слайд 3Среды могут быть мягкими и твердыми, простыми и сложными, универсальными и
не очень, однако во всех случаях они должны обеспечивать питание, дыхание, размножение и рост бактериальной клетки.
Слайд 4Некоторые среды
(тиогликолевая, Сабуро) подходят для широкого круга микроорганизмов и называются
универсальными. Другие же предназначены только для определенных видов, например, пневмококк и золотистый стафилококк, продуцирующие гемолизины, растут на кровяном агаре, который служит для выделения особо «капризных» и, вместе с тем, опасных штаммов. Таким образом, разновидностей сред множество, где каждая из них выращивает свой круг микроорганизмов
Слайд 5Цель культивирования микроорганизмов и значимость ее для диагностики
Кроме воды, воздуха, почвы,
содержащие в тех или иных концентрациях различные микроорганизмы, в том числе и приносящие болезнь (патогенные), многие отрасли медицинской науки интересуют микробы, живущие на коже и слизистых человеческого организма, которые могут быть представлены:
Слайд 6 Постоянными обитателями, не несущими никакой опасности человеку, то есть, нормальной микрофлорой
организма, без которой мы просто жить не можем. Например, исчезновение бактерий, живущих в кишечнике и участвующих в процессе пищеварения, приводит к дисбактериозу, лечить который – дело непростое. Так же происходит и с исчезновением вагинальной микрофлоры. Ее тут же заселяют условно-патогенные микроорганизмы, гарднереллы, например, которые вызывают бактериальный вагиноз (гарднереллез);
Микроорганизмы микрофлоры кожи
Слайд 7 Условно-патогенной флорой, которая приносит вред лишь в больших количествах при определенных
условиях (иммунодефицит). Вышеназванная гарднерелла – представитель такого типа микроорганизмов;
Стафилококки
Условно-патогенная флора кишечника
Слайд 8Наличие патогенных микробов
Наличием патогенных микробов, которые в здоровом теле не
присутствуют. Они чужды человеческому организму, куда попадают случайно при контакте с другим (больным) человеком и вызывают развитие инфекционного процесса, порой, довольно тяжелого или даже смертельного.
Золотистый стафилококк
Слайд 9Когда назначается бак посев и как разобраться в ответах?
Бактериологический анализ пациенты
сами себе не назначают, это делает врач, если у него есть подозрения, что проблемы больного, предъявляющего различные жалобы, связаны с проникновением в организм патогенного возбудителя или с усиленным размножением микроорганизмов, постоянно живущих с человеком, но проявляющих патогенные свойства только в определенных условиях.
Слайд 101. Первым пунктом заключения, как правило, стоит название возбудителя на латинском языке,
например, Escherichia coli. Это – кишечная палочка, она является естественным обитателем кишечника и в допустимых количествах никакого вреда не приносит.
Слайд 112.Следующий пункт – концентрация микроорганизма. Е. coli– обильный рост (1х10^6 и более) норма –
менее 1x10^4;
Слайд 13При исследовании биологического материала на присутствие патогенных микроорганизмов ответ может быть
отрицательным или положительным («плохой бак посев»), поскольку организм человека является для них лишь временным пристанищем, а не естественной средой обитания.
Слайд 14Иной раз, в зависимости от того, какой материал подлежит посеву, можно
увидеть количество микроорганизмов, выраженное в колониеобразующих единицах на мл (одна живая клетка даст рост целой колонии) – КОЕ/мл. Например, посев мочи для бактериологического исследования при норме дает до 103 КОЕ/мл всех выявленных бактериальных клеток, в сомнительных случаях (анализ повторить!) – 103 – 104 КОЕ/мл, при воспалительном процессе инфекционного происхождения – 105 и выше КОЕ/мл. О двух последних вариантах в разговорной речи, порой, выражаются просто: «Плохой бак посев».
Макро-ло тест для индефикация бактерий
Слайд 15Правильная подготовка к бактериологическому анализу
Бактериологическому анализу может подвергаться любой биологический материал,
взятый у человека (кожа, кровь, сперма, слизистые ротовой полости, дыхательных и мочеполовых путей, желудочно-кишечного тракта, органов зрения, слуха и обоняния и др.).
Слайд 16Правильная подготовка к бактериологическому посеву будет залогом правильного результата, потому что
в противном случае, анализ придется сдавать заново и ждать назначенное время. Как сдать кровь на стерильность из вены – это задача медработников. От больного здесь, как правило, ничего не зависит, он просто предоставляет локтевой сгиб, а медсестра производит забор в стерильную пробирку с соблюдением всех правил асептики и антисептики.
Слайд 17Биохимическая идентификация
Классический (традиционный) метод идентификации микробов по биохимическим признакам заключается
в посеве чистой культуры на дифференциально-диагностические среды, содержащие определенные субстраты, с целью оценки способности микроорганизма ассимилировать данный субстрат или определения конечных продуктов его метаболизма. Исследование занимает не менее 1 сут. Примером является оценка саха-ролитической активности бактерий (способности ферментировать углеводы) с помощью посева на среды Гисса — короткий и длинный "пестрый ряд".
Слайд 18Биохимические и молекулярно-генетические методы идентификации
Хемоидентификация — идентификация по химическому составу микробной
клетки. В состав любого организма входят 4 основных класса биомолекул: нуклеиновые кислоты, белки, углеводы и липиды. Хемоидентификация основана в первую очередь на анализе состава микробных липидов, поскольку среди биополимеров они характеризуются наибольшим разнообразием мономеров
Слайд 19Итог : проводя анализ посева можно столкнуться с некоторыми трудностями :
неправильный забор переданного материала ,присутствие других патогенных бактерий из внешней среды .
Стоит так же учитывать нормы хранения биоматериала .
С помощью идентификации можно определить наличие патогенных бактерий ,принадлежность их к определенной группе и способы воздействия на них.
Стоит так же учитывать нормы хранения биоматериала .
С помощью идентификации можно определить наличие патогенных бактерий ,принадлежность их к определенной группе и способы воздействия на них.